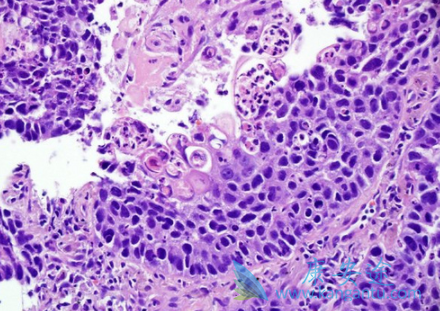
����״ϸ����

肺鳞状细胞癌约占非小细胞肺癌(NSCLC)的30%,90%与吸烟有关,中央型多见,倍增时间较长。虽然肺鳞状细胞癌及肺腺癌均发生于同一器官,但在基因组学方面有显著差别。目前,肺鳞状细胞癌仍缺少可利用的基因突变,肺鳞状细胞癌的靶向治疗研究进展缓慢。那目前肺鳞状细胞癌的治疗药物有哪些呢?
晚期肺鳞状细胞癌EGFR突变阳性使用吉非替尼、厄罗替尼或阿法替尼,ALK融合或ROS1融合阳性使用克唑替尼,EGFR、ALK和ROS1阴性且PD-L1表达强阳使用Pembrolizumab,其它情况使用化疗方案。EGFR单抗Necitumumab于2015年被FDA批准用于联合含铂化疗一线治疗肺鳞癌,然而总生存期仅提高1.6个月,收益有限未被纳入NCCN治疗指南。
二线治疗:EGFR突变:奥希替尼。ALK融合:色瑞替尼,艾乐替尼。PD-1/PD-L1抑制剂:Nivolumab,Pembrolizumab,Atezolizumab。化疗:吉西他滨,多西紫杉醇,多西紫杉醇联合雷莫芦单抗。肺鳞状细胞癌的其它治疗靶点:MET扩增或EXON 14跳跃突变:克唑替尼。HER2突变:阿法替尼,曲妥珠单抗联合长春瑞滨或多西他赛。BRAFV600E突变:威罗菲尼,达拉非尼,达拉非尼联合曲美替尼。RET融合:卡博替尼,凡德他尼,凡德他尼联合依维莫司。
详情请访问 肿瘤 https://www.kangantu.com/
















请简单描述您的疾病情况,我们会有专业的医学博士免费为您解答问题(24小时内进行电话回访)